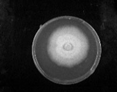
Molecules 27 07746 i006 Molecules 27 07746 i006
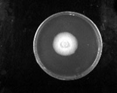
Molecules 27 07746 i008 Molecules 27 07746 i008
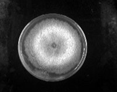
Molecules 27 07746 i013 Molecules 27 07746 i013

Emulsifying Properties of Rhamnolipids and Their In Vitro Antifungal Activity against Plant Pathogenic Fungi
Abstract
Simple Summary
Abstract
1. Introduction
2. Materials and Methods
2.1. Production, Purification and Characterization of Rhamnolipid Products
2.2. Materials and Fungi
2.3. Determination of the Critical Micelle Concentration (CMC) of Rhamnolipids
2.4. Determination of the Emulsification
2.5. In vitro Bioassay for Antifungal Activity
2.5.1. Evaluation of Suppression of Mycelial Growth
2.5.2. Antifungal Activity against Fungal Spores
2.6. Data Analysis
3. Results
3.1. Proportions of Rhamnolipid Products
3.2. The Critical Micelle Concentration (CMC)
3.3. Emulsifying Activity of Rhamnolipids on Solvents in Pesticides
3.3.1. Emulsification of Chemical Emulsifiers and Rhamnolipids
3.3.2. The Effect of pH on Emulsification
3.3.3. Emulsification Layer and Emulsified Particles Formed by Rhamnolipid Products
3.4. Evaluation of Antifungal Activity of Rhamnolipid in Vitro
3.4.1. Suppression of Mycelial Growth
3.4.2. Suppression of Spore Germination
4. Discussion
5. Conclusions
Author Contributions
Funding
Institutional Review Board Statement
Informed Consent Statement
Data Availability Statement
Acknowledgments
Conflicts of Interest
References
- Chong, H.Q.; Li, Q.X. Microbial production of rhamnolipids: Opportunities, challenges and strategies. Microb. Cell. Fact. 2017, 16, 137. [Google Scholar] [CrossRef] [PubMed]
- Santos, E.C.; Jacques, R.J.S.; Bento, F.M.; Peralba, M.D.R.; Selbach, P.A.; Sa, E.L.S.; Camargo, F.A.O. Anthracene biodegradation and surface activity by an iron-stimulated Pseudomonas sp. Bioresource. Technol. 2007, 99, 2644–2649. [Google Scholar] [CrossRef] [PubMed]
- Mulligan, C.N. Recent advances in the environmental applications of biosurfactants. Curr. Opin. Colloid. Interface Sci. 2009, 14, 372–378. [Google Scholar] [CrossRef]
- Thakur, P.; Saini, N.K.; Thakur, V.K.; Gupta, V.K.; Saini, R.V.; Saini, A.K. Rhamnolipid the Glycolipid Biosurfactant: Emerging trends and promising strategies in the field of biotechnology and biomedicine. Microb. Cell. Fact. 2021, 20, 1. [Google Scholar] [CrossRef] [PubMed]
- Shen, C.; Jiang, L.F.; Shao, H.W.; You, C.G.; Zhang, G.L.; Ding, S.T.; Bian, T.W.; Han, C.M.; Meng, Q. Targeted killing of myofibroblasts by biosurfactant di-rhamnolipid suggests a therapy against scar formation. Sci. Rep. 2016, 6, 37553. [Google Scholar] [CrossRef] [PubMed]
- Monteiro, S.A.; Sassaki, G.L.; de Souza, L.M.; Meira, J.A.; de Araujo, J.M.; Mitchell, D.A.; Ramos, L.P.; Krieger, N. Molecular and structural characterization of the biosurfactant produced by Pseudomonas aeruginosa DAUPE 614. Chem. Phys. Lipids. 2007, 147, 1–13. [Google Scholar] [CrossRef]
- Wittgens, A.; Santiago-Schuebel, B.; Henkel, M.; Tiso, T.; Blank, L.M.; Hausmann, R.; Hofmann, D.; Wilhelm, S.; Jaeger, K.E.; Rosenau, F. Heterologous production of long-chain rhamnolipids from Burkholderia glumae in Pseudomonas putida-a step forward to tailor-made rhamnolipids. Appl. Microbiol. Biotechnol. 2018, 102, 1229–1239. [Google Scholar] [CrossRef]
- Rocha, V.A.L.; de Castilho, L.V.A.; de Castro, R.P.V.; Teixeira, D.B.; Magalhaes, A.V.; Gomez, J.G.C.; Freire, D.M.G. Comparison of mono-rhamnolipids and di-rhamnolipids on microbial enhanced oil recovery (MEOR) applications. Biotechnol. Prog. 2020, 36, e2981. [Google Scholar] [CrossRef]
- Henkel, M.; Geissler, M.; Weggenmann, F.; Hausmann, R. Production of microbial biosurfactants: Status quo of rhamnolipid and surfactin towards large-scale production. Biotechnol. J. 2017, 12, 1600561. [Google Scholar] [CrossRef]
- Li, Z.; Zhang, Y.; Lin, J.; Wang, W.; Li, S. High-Yield Di-Rhamnolipid Production by Pseudomonas aeruginosa YM4 and its Potential Application in MEOR. Molecules 2019, 24, 1433. [Google Scholar] [CrossRef]
- Wu, L.M.; Lai, L.; Lu, Q.; Mei, P.; Wang, Y.Q.; Cheng, L.; Liu, Y. Comparative studies on the surface/interface properties and aggregation behavior of mono-rhamnolipid and di-rhamnolipid. Colloids Surf. B Biointerfaces 2019, 181, 593–601. [Google Scholar] [CrossRef]
- Stanghellini, M.E.; Miller, R.M. Biosurfactants: Their Identity and Potential Efficacy in the Biological Control of Zoosporic Plant Pathogens. Plant Dis. 1997, 81, 4–12. [Google Scholar] [CrossRef]
- Guo, Y.P.; Hu, Y.Y.; Gu, R.R.; Lin, H. Characterization and micellization of rhamnolipidic fractions and crude extracts produced by Pseudomonas aeruginosa mutant MIG-N146. J. Colloid. Interface Sci. 2009, 331, 356–363. [Google Scholar] [CrossRef]
- Silva, S.N.R.L.; Farias, C.B.B.; Rufino, R.D.; Luna, J.M.; Sarubbo, L.A. Glycerol as substrate for the production of biosurfactant by Pseudomonas aeruginosa UCP0992. Colloid. Surf. B 2010, 79, 174–183. [Google Scholar] [CrossRef]
- Hultberg, M.; Bengtsson, T.; Liljeroth, E. Late blight on potato is suppressed by the biosurfactant-producing strain Pseudomonas koreensis 2.74 and its biosurfactant. Biocontrol 2010, 55, 543–550. [Google Scholar] [CrossRef]
- Kim, B.S.; Lee, J.Y.; Hwang, B.K. In vivo control and in vitro antifungal activity of rhamnolipid B, a glycolipid antibiotic, against Phytophthora capsici and Colletotrichum orbiculare. Pest. Manag. Sci. 2000, 56, 1029–1035. [Google Scholar] [CrossRef]
- Das, P.; Yang, X.P.; Ma, L.Z. Analysis of biosurfactants from industrially viable Pseudomonas strain isolated from crude oil suggests how rhamnolipids congeners affect emulsification property and antimicrobial activity. Front. Microbiol. 2014, 5, 696. [Google Scholar] [CrossRef]
- Hajimohammadi, R.; Johari-ahar, S. Determination of optimal parameters of rhamnolipid biosurfactant production: An agent for emulsification of heavy crude oil. Pet. Sci. Technol. 2018, 36, 186–192. [Google Scholar] [CrossRef]
- Lovaglio, R.B.; dos Santos, F.J.; Jafelicci, M., Jr.; Contiero, J. Rhamnolipid emulsifying activity and emulsion stability: pH rules. Colloids Surf. B Biointerfaces 2011, 85, 301–305. [Google Scholar] [CrossRef]
- Onaizi, S.A.; Alsulaimani, M.; Al-Sakkaf, M.K.; Bahadi, S.A.; Mahmoud, M.; Alshami, A. Crude oil/water nanoemulsions stabilized by biosurfactant: Stability and pH-Switchability. J. Pet. Sci. Eng. 2021, 198, 108173. [Google Scholar] [CrossRef]
- Park, Y.H.; Kim, H.J. Formulation and stability of horse oil-in-water emulsion by HLB system. Food. Sci. Biotechnol. 2021, 30, 931–938. [Google Scholar] [CrossRef] [PubMed]
- Zhou, J.; Xue, R.; Liu, S.; Xu, N.; Xin, F.; Zhang, W.; Jiang, M.; Dong, W. High Di-rhamnolipid Production Using Pseudomonas aeruginosa KT1115, Separation of Mono/Di-rhamnolipids, and Evaluation of Their Properties. Front. Bioeng. Biotechnol. 2019, 7, 245. [Google Scholar] [CrossRef] [PubMed]
- Feng, J.; Chen, Q.; Wu, X.; Jafari, S.M.; McClements, D.J. Formulation of oil-in-water emulsions for pesticide applications: Impact of surfactant type and concentration on physical stability. Environ. Sci. Pollut. Res. Int. 2018, 25, 21742–21751. [Google Scholar] [CrossRef] [PubMed]
- Liu, W.; Sun, D.; Li, C.; Liu, Q.; Xu, J. Formation and stability of paraffin oil-in-water nano-emulsions prepared by the emulsion inversion point method. J. Colloid Interface Sci. 2006, 303, 557–563. [Google Scholar] [CrossRef] [PubMed]
- Mansour, S.A.; Belal, M.H.; Abou-Arab, A.A.K.; Ashour, H.M.; Gad, M.F. Evaluation of some pollutant levels in conventionally and organically farmed potato tubers and their risks to human health. Food. Chem. Toxicol. 2009, 47, 615–624. [Google Scholar] [CrossRef]
- Togni, P.H.B.; Venzon, M.; Lagoa, A.C.G.; Sujii, E.R. Brazilian Legislation Leaning Towards Fast Registration of Biological Control Agents to Benefit Organic Agriculture. Neotrop. Entomol. 2019, 48, 175–185. [Google Scholar] [CrossRef]
- Karthika, S.; Varghese, S.; Jisha, M.S. Exploring the efficacy of antagonistic rhizobacteria as native biocontrol agents against tomato plant diseases. 3 Biotech 2020, 10, 320. [Google Scholar] [CrossRef]
- Lahkar, J.; Goswami, D.; Deka, S.; Ahmed, G. Novel approaches for application of biosurfactant produced by Pseudomonas aeruginosa for biocontrol of Colletotrichum capsici responsible for anthracnose disease in chilli. Eur. J. Plant Pathol. 2017, 150, 57–71. [Google Scholar] [CrossRef]
- Goswami, D.; Borah, S.N.; Lahkar, J.; Handique, P.J.; Deka, S. Antifungal properties of rhamnolipid produced by Pseudomonas aeruginosa DS9 against Colletotrichum falcatum. J. Basic Microbiol. 2015, 55, 1265–1274. [Google Scholar] [CrossRef]
- Goswami, D.; Handique, P.J.; Deka, S. Rhamnolipid biosurfactant against Fusarium sacchari—The causal organism of pokkah boeng disease of sugarcane. J. Basic Microbiol. 2014, 54, 548–557. [Google Scholar] [CrossRef]
- Soltani Dashtbozorg, S.; Miao, S.; Ju, L.-K. Rhamnolipids as environmentally friendly biopesticide against plant pathogen Phytophthora sojae. Environ. Prog. Sustain. Energy 2016, 35, 169–173. [Google Scholar] [CrossRef]
- Borah, S.N.; Goswami, D.; Sarma, H.K.; Cameotra, S.S.; Deka, S. Rhamnolipid Biosurfactant against Fusarium verticillioides to Control Stalk and Ear Rot Disease of Maize. Front. Microbiol. 2016, 7, 1505. [Google Scholar] [CrossRef]





| Strain | Rhamnolipids | Purity % | Homolog Ratio % | ||
|---|---|---|---|---|---|
| Rha2-C10-C10 | Rha-C10-C10 | Others | |||
| PAO1 | DR25 | 60.31 | 25.45 | 66.78 | 7.77 |
| HN | DR46 | 65.39 | 46.46 | 43.86 | 9.68 |
| YM4 | DR90 | 79.65 | 89.52 | 5.96 | 4.52 |
| Emulsifier | Solvents | ||
|---|---|---|---|
| S-200 | Xylene | Cyclohexanone | |
| DR25 | ++ | ++ | - |
| DR46 | ++ | ++ | - |
| DR90 | ++ | ++ | - |
| EL-40 | +++ | +++ | - |
| SDS | ++ | ++ | +++ |
| pH Value | S-200 | Xylene | Cyclohexanone | ||||||
|---|---|---|---|---|---|---|---|---|---|
| DR25 | DR46 | DR90 | DR25 | DR46 | DR90 | DR25 | DR46 | DR90 | |
| 5.5 | + | + | + | + | + | + | - | - | - |
| 7.0 | ++ | ++ | ++ | ++ | ++ | ++ | - | - | - |
| 8.5 | +++ | +++ | +++ | +++ | +++ | +++ | - | - | - |
| Fungi | Control | Inhibition Rate % | ||
|---|---|---|---|---|
| DR25 | DR46 | DR90 | ||
| P. capsici | ![]() | ![]() 62.89 ± 4.01 | ![]() 71.22 ± 1.98 | ![]() 100 |
| P. nicotianae | ![]() | ![]() 29.10 ± 1.31 | ![]() 34.26 ± 1.10 | ![]() 66.21 ± 3.06 |
| C.sublineolum | ![]() | ![]() 42.59 ± 2.43 | ![]() 72.42 ± 0.53 | ![]() 79.27 ± 2.15 |
| F. oxysporum | ![]() | ![]() 40.07 ± 1.54 | ![]() 70.94 ± 2.47 | ![]() 78.03 ± 2.40 |
| C. destructivum. | ![]() | ![]() 59.97 ± 0.95 | ![]() 66.57 ± 0.62 | ![]() 78.68 ± 3.06 |
Publisher’s Note: MDPI stays neutral with regard to jurisdictional claims in published maps and institutional affiliations. |
© 2022 by the authors. Licensee MDPI, Basel, Switzerland. This article is an open access article distributed under the terms and conditions of the Creative Commons Attribution (CC BY) license (https://creativecommons.org/licenses/by/4.0/).
Share and Cite
Li, D.; Tao, W.; Yu, D.; Li, S. Emulsifying Properties of Rhamnolipids and Their In Vitro Antifungal Activity against Plant Pathogenic Fungi. Molecules 2022, 27, 7746. https://doi.org/10.3390/molecules27227746
Li D, Tao W, Yu D, Li S. Emulsifying Properties of Rhamnolipids and Their In Vitro Antifungal Activity against Plant Pathogenic Fungi. Molecules. 2022; 27(22):7746. https://doi.org/10.3390/molecules27227746
Chicago/Turabian StyleLi, Dongmei, Weiyi Tao, Dinghua Yu, and Shuang Li. 2022. "Emulsifying Properties of Rhamnolipids and Their In Vitro Antifungal Activity against Plant Pathogenic Fungi" Molecules 27, no. 22: 7746. https://doi.org/10.3390/molecules27227746
APA StyleLi, D., Tao, W., Yu, D., & Li, S. (2022). Emulsifying Properties of Rhamnolipids and Their In Vitro Antifungal Activity against Plant Pathogenic Fungi. Molecules, 27(22), 7746. https://doi.org/10.3390/molecules27227746